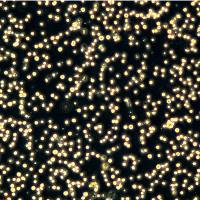
浙江美森-人成巨核细胞白血病细胞 MEG-01

相关产品推荐更多 >
万千商家帮你免费找货
0 人在求购买到急需产品
- 详细信息
- 询价记录
- 文献和实验
- 技术资料
- 库存:
1
- 物种来源:
人
- 细胞形态:
贴壁
- 规格:
T25
风险提示:丁香通仅作为第三方平台,为商家信息发布提供平台空间。用户咨询产品时请注意保护个人信息及财产安全,合理判断,谨慎选购商品,商家和用户对交易行为负责。对于医疗器械类产品,请先查证核实企业经营资质和医疗器械产品注册证情况。
- 作者
- 内容
- 询问日期
文献和实验thx221 有没有哪位大侠做内皮细胞方面的信号转导的???帮忙给提供几个通路做参考!或者给我点相关的最新研究文献!我实在是找不到这方面的最新研究进展,大家帮个忙吧!先谢谢了!!! 编年张 加此QQ492207858 chuckdouble thx221 wrote: 有没有哪位大侠做内皮细胞方面的信号转导的???帮忙给提供几个通路做参考!或者给我点相关
实验材料: 1. 正常人角膜移植供体角膜 2. 胰蛋白酶/EDTA液:0.05%胰蛋白酶,0.5mmol/L EDTA 3. KGM:无血清角质形成细胞培养液,添加0.15mmol/L 钙、0.1ng/ml 人上皮生长因子、5mg/ml 胰岛素、0.5mg/ml 氢化可的松和30mg/ml 牛垂体提取物;MEM;PBSA;胎牛血清 4. FNC:10mg/ml 纤连蛋白、35ug/ml 胶原蛋白和100mg/ml BSA(bovine serum albumin)。BSA
hbsyliuyang rt 请不吝赐教 感谢! david_xmu 没什么太大的区别,另外内皮细胞在不同的培养基中培养可能会有形态上的区别 hbsyliuyang 谢谢这位达人! 拜 本文由丁香园论坛提供,想了解更多有用的、有意思的前沿资讯以及酷炫的实验方法的你,都可以成为师兄的好伙伴 师兄微信号:shixiongcoming
技术资料暂无技术资料 索取技术资料